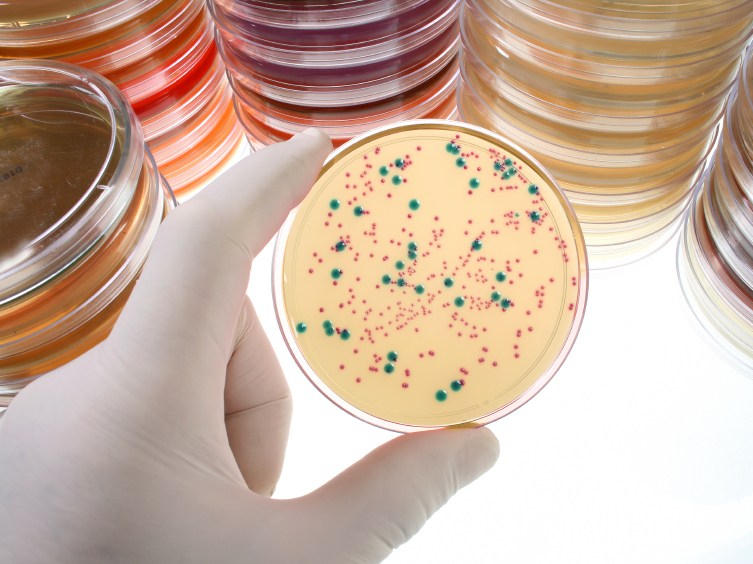

The State of the Species is a 2012 article by journalist and author Charles Mann. In this article Mann presents his theory of where Homo Sapiens are as species and ponders the question of whether Homo Sapiens are truly a unique and special species, or will time ultimately prove us to be no more remarkable than simple protozoan life?
Mann explains it is evident when a species is unchecked by resource limitations or predation, the population of said species will grow exponentially until it hits an inflection point and the population crashes. He uses the example of protozoa in a petri dish to demonstrate this phenomenon. When protozoa are placed in a petri dish and have no limits to their access to energy, are unchecked by the size of their habitat, and are not subject to competition by other organisms, the protozoa will continue to reproduce until they overwhelm their environment and the population collapses. So are humans any different?
Thanks to a few evolutionary advantages, Homo Sapiens have been enjoying a, geologically speaking, brief moment of success. Our highly developed brains have allowed our species to reproduce rapidly and dominate all corners of the globe. It appears we have reached a moment where we are no longer bound by environmental limits. We have unlimited access to habitat, food, water, and energy and we have no natural predators acting as a cap on our growth. We have seemingly slipped the shackles of natural selection. But how long lived will this success be?
As our species continues to grow, unrestricted by the laws that seem to constrain all other forms of life, we must ask ourselves if we are truly special or if we, like the protozoa in the petri dish, are sprinting full speed towards the abyss. We are aware of the damage our unrestricted growth is doing to our petri dish. We can quantify the waste generated by our species and model the effects. We know our species’ unchecked consumption of resources and secretion of waste is damaging the systems that make the success of our species possible. However, time and time again, our species seems unable to demonstrate an ability to actually enforce limits on our growth and prevent destruction.
As Mann points out, a species wide limit on growth and systemic restriction of resource consumption is evolutionarily unprecedented. With all of our intellect, technology, and self-awareness; are humans an exception to this rule? Will we prove to be a special species and enforce the limits and restrictions needed to avoid collapse? Or will we, like the protozoa, continue to expand exponentially until our petri dish can no longer support us and we annihilate ourselves, drowning in our own waste or starving from lack of food? In the end, are humans more intelligent than protozoa?
Read Charles Mann’s full article here.